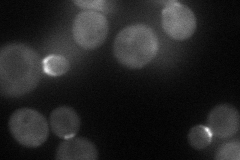
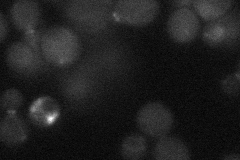
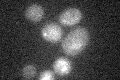

View description
Protein kinase of the bud neck involved in the septin checkpoint, associates with septin proteins, negatively regulates Swe1p by phosphorylation, shows structural homology to bud neck kinases Gin4p and Hsl1p
Localization:
Intensity:
Fold change:
Significance:
-
C’ GFP library in SD

bud neckN/A -
N' NOP1pr-GFP in SD
bud neck53.0701 -
N' TEF2pr-mCherry in SD

bud neck25.3922 -
N' NATIVEpr-GFP in SD
bud neck22.9346 -
N' TEF2pr-VC and Cyto-VN in SD

bud neck31.0933 -
C’ GFP library in SD+DTT

bud neck19.221.02No -
C’ GFP library in SD+H2O2

bud neck21.321.13No -
C’ GFP library in Starvation Media
bud neck17.850.94No -
C’ GFP library on the background of Pup2-DaMP

bud neck -
C’ GFP library on the background of CCT mutant

bud neck21.22361.12818No
